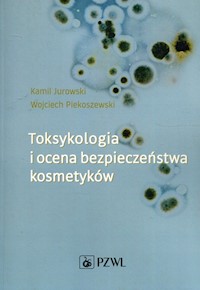
Toksykologia i ocena bezpieczeństwa kosmetyków - Jurowski Kamil, Piekoszewski Wojciech - książka

Dostawa: od 6,99 zł (darmowa dostawa z abonamentem Legimi)
Czas wysyłki: 1-2 dni robocze + czas dostawy
Dostawa: od 6,99 zł (darmowa dostawa z abonamentem Legimi)
Czas wysyłki: 1-2 dni robocze + czas dostawy
Dowiedz się więcej.
Dwuczęściowa Toksykologia w zadaniach to nowoczesna publikacja, która została napisana z myślą o studentach medycyny, farmacji, diagnostyki medycznej, kierunków przyrodniczych. Stanowi ona także doskonałe źródło pomocy dla wykładowców podczas przygotowywania zajęć oraz zaliczeń. Ponadto jest kompatybilna z dwutomowym podręcznikiem Toksykologia oraz stanowi jego uzupełnienie. Zaprezentowane w publikacji rozdziały zostały zawierają pełne rozwiązania zadań oraz ważne komentarze, wyjaśniające poruszaną kwestię. Redaktorami naukowymi książki są dr Kamil Jurowski (toksykolog, safety assessor) oraz prof. dr hab. Wojciech Piekoszewski (specjalista z zakresu toksykologii: sądowej, klinicznej, ekotoksykologii i żywności).
W części 1 Toksykologii w zadaniach zostały zaprezentowane historia toksykologii, toksykologia ogólna oraz toksykologia narządowa i układowa.
W części 2 przedstawiono wybrane zagadnienia z toksykologii szczegółowej (toksykologia wybranych metali, trucizny obecne w roślinach oraz pochodzące od zwierząt, toksykologia substancji uzależniających, pestycydów oraz bojowe środki trujące) oraz toksykologii stosowanej (toksykologia analityczna i analiza toksykologiczna, toksykologia kliniczna, sądowa, weterynaryjna i środowiskowa, laboratoryjna toksykologia medyczna, toksykoproteomika, toksykologia i ocena bezpieczeństwa żywności i żywienia oraz toksykologia kosmetyków i ocena bezpieczeństwa produktów kosmetycznych, ekotoksykologia, nanotoksykologia, a także toksykologiczna ocena ryzyka zdrowotnego). W części 2 Toksykologii w zadaniach zostały zaprezentowane wybrane zagadnienia z toksykologii szczegółowej (toksykologia wybranych metali, trucizny obecne w roślinach oraz pochodzące od zwierząt, toksykologia substancji uzależniających, pestycydów oraz bojowe środki trujące) oraz toksykologii stosowanej (toksykologia analityczna i analiza toksykologiczna, toksykologia kliniczna, sądowa, weterynaryjna i środowiskowa, laboratoryjna toksykologia medyczna, toksykoproteomika, toksykologia i ocena bezpieczeństwa żywności i żywienia oraz toksykologia kosmetyków i ocena bezpieczeństwa produktów kosmetycznych, ekotoksykologia, nanotoksykologia, a także toksykologiczna ocena ryzyka zdrowotnego). W części 1 odbiorca znajdzie zadania dotyczące historii toksykologii, toksykologii ogólnej oraz toksykologii narządowej i układowej. Należy zaznaczyć, że do każdego rozdziału zostały dołączone pełne rozwiązania zadań oraz ważne komentarze, wyjaśniające poruszaną kwestię. Istotnym jest również to, że Toksykologia w zadaniach jest kompatybilna z dwutomowym podręcznikiem Toksykologia oraz stanowi jego uzupełnienie.
Liczba stron: 455
Rok wydania: 2024
Format (wymiary): 16.5x23.5cm
ISBN: 9788301235789
Wydanie: 1